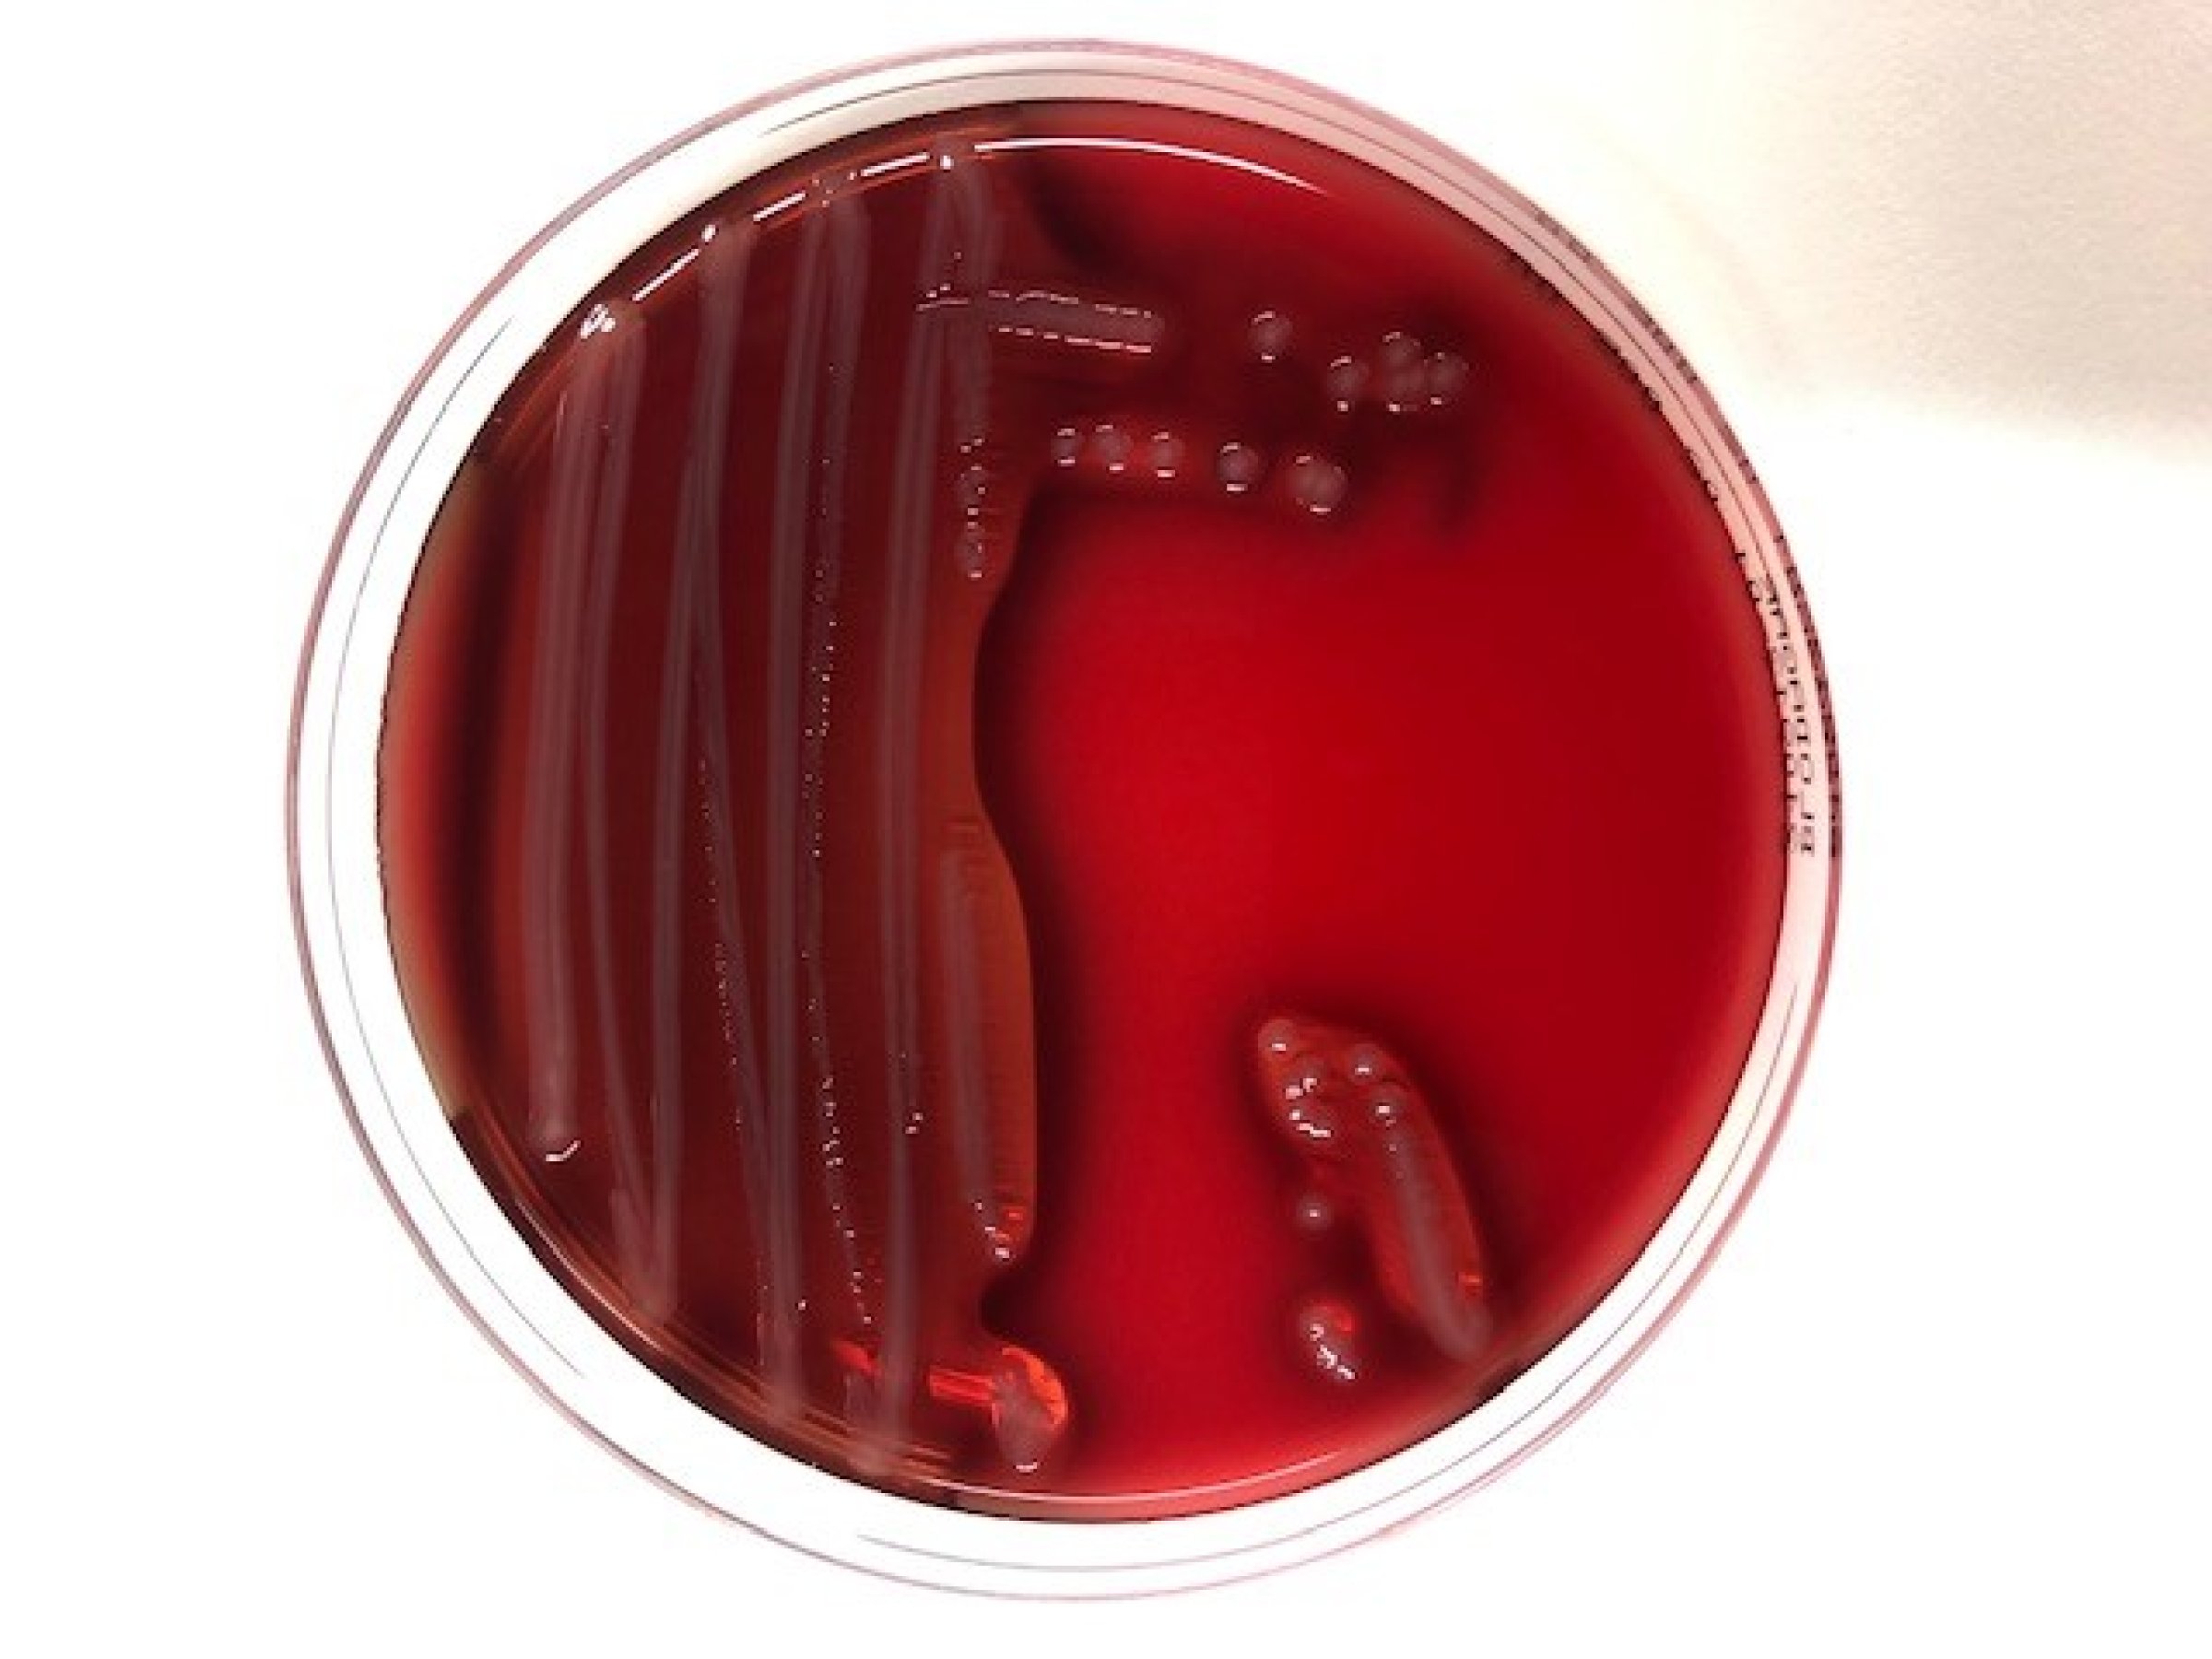

Presiserer prinsipper for helsekontroll og dokumentasjon ved utsett eller flytting av fisk
Denne saken er eldre enn to år
Det siste året har det i enkelte anlegg vært høy dødelighet hos fisk like etter utsett av smolt eller flytting av fisk. Det har også vært tilfeller der alvorlig sykdom er påvist i grupper med nylig utsatt smolt.
Tilfellene reiser spørsmål om helsestatus i tilstrekkelig grad blir kartlagt før utsetting, og om testing og dokumentasjon av fiskens fysiologiske status er god nok.
Veterinærinstituttet og Mattilsynet har derfor presisert en del viktige prinsipper for diagnostikk og risikobasert helsekontroll.
Les mer om helsekontroll og dokumentasjon ved utsett eller flytting av fisk her.